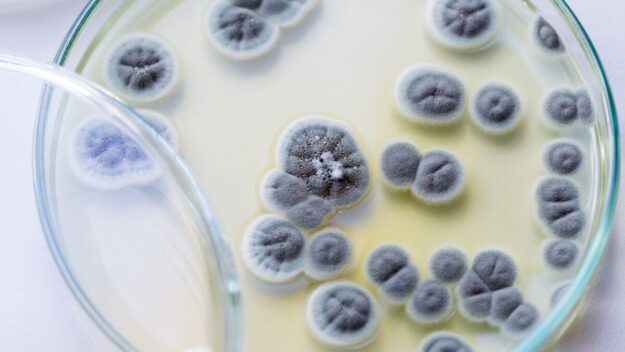

Proverbs 18:11
A rich man’s wealth is his strong city, and like a high wall in his imagination. [Proverbs 18:11 ESV] We attach great importance to the here and now. The past and the future often fall out of sight, all our thought turned to the foreground. Then the past comes into focus, the future arrives, and…
Details